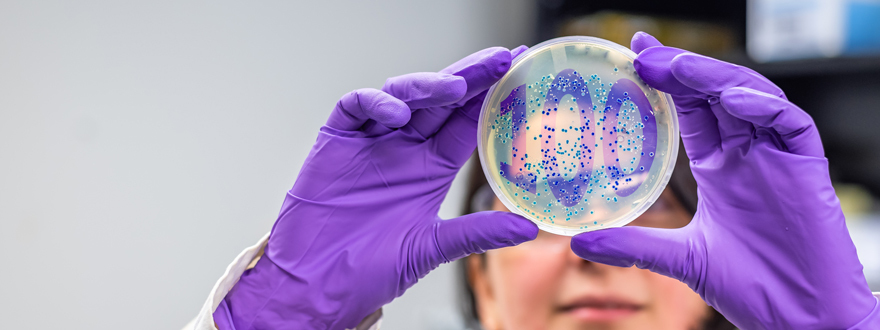

Biochemistry – Celebrating a century of groundbreaking research
By Cam Buchan
 Greg Gloor, PhD
Greg Gloor, PhD
Chair of the Department of Biochemistry
Since its beginning in 1924, the Biochemistry Department at Schulich School of Medicine & Dentistry has been on the frontlines of research, teaching and training, breaking new ground in solving the health challenges of each generation.
From the early days – when the department specialized in carbohydrate metabolism, and the study of diabetes – to today, when its researchers are on the cutting edge of cancer biology, vascular biology, aging, infection and more, the department has inspired the next generation of scientists and educators.
As it celebrates a century of research, we caught up with Greg Gloor, PhD, and Chair of the Department of Biochemistry, to find out more about the past, present and future of this dynamic department.
As Biochemistry celebrates its 100th anniversary, describe the strengths of the department from your point of view.
Our department boasts a remarkable diversity of research strengths, spanning various facets of biochemistry and molecular biology. I would describe it as a department of unicorns – everybody is different and has their own unique research strengths. Everyone in the group is either a leader in their particular field or they are emerging as a leader. There is no problem they can’t solve if they put their minds to it. It really doesn’t matter who I am talking about – the faculty in the Department identify problems and use the tools in their toolkits to solve them. No matter what you bring to me, I can say I have someone working on that. Is it neurobiology, atherosclerosis, cardiovascular, sepsis, cancer, women’s health? I can say we’re on it. That’s what I mean by a diversity of research strengths.
Our department has also demonstrated the ability to evolve with emerging technologies. Biochemistry serves as a core molecular science, providing the mechanistic framework to understand phenomena across all domains of life. This foundational role, combined with our understanding and development of new technologies, underscores the department's significance in advancing scientific knowledge.
What are some of the opportunities the department can take advantage of going forward?
One opportunity for our department lies in integrating computational predictive methods into our research. Computational predictive methods use computer algorithms and mathematical models to predict outcomes based on data. A few examples of these computational approaches include bioinformatics, machine learning and artificial intelligence. They are a way of advancing research and innovation across a wide range of disciplines in health and science, helping researchers make data-driven decisions in their respective fields. There are several groups working on computationally predictive methods for a variety of projects, whether it’s protein function, medication usage in women, or CRISPR targeting.
Another opportunity is that advancements in infrastructure will empower us to conduct increasingly sophisticated experiments, positioning biochemistry at the forefront of scientific innovation.
Can you explain what metabolomics is and how it contributes to scientific research?
We're also building our ecosystem at Schulich around metabolomics and Biochemistry is going to play a very large role here. Metabolomics is a powerful tool that allows scientists to explore the complex metabolic networks within living organisms and gain insights into health, disease and physiological processes. It’s basically taking a snapshot of all the small molecules (metabolites) in a biological sample, such as blood, urine, or tissue. These metabolites are the products of various biochemical processes that occur within cells and tissues, and they can provide valuable insights into the metabolic state of an organism. It’s like monitoring the traffic flow of molecules in a busy city (your body) at a particular moment. Researchers can learn a lot about how your body is functioning and how it responds to different conditions, such as disease, diet, or medication from this information.
Outline the importance of collaboration in this field?
Basically, everyone in this department collaborates, both internally and externally. Whether it's with other scientists, clinicians, or community partners, collaboration is a major aspect of our department's culture. We excel in intricate details but sometimes need help with big-picture questions. Balancing teamwork with individual research is key. When I interviewed faculty members recently, I was impressed by the level of collaboration happening, which I think is quite unique.
Reflecting on the department's rich history, could you highlight three of the most significant discoveries made over the past century?
Three notable discoveries include Roger Rossiter's pioneering work in neurochemistry, particularly his establishment of research programs and foundational contributions to understanding myelin-based diseases. Fred Possmayer's groundbreaking insights into pulmonary surfactant as a treatment for complications of neonatal respiratory distress is another. Additionally, Rob Hegele's discoveries explaining the genetic underpinnings of dyslipidemias and other monogenic human disorders have significantly advanced our understanding of inherited conditions.
As you look ahead, what do you see as the next-generation breakthrough?
I believe the next major breakthrough will likely involve the development of designer drugs based on computational modeling, tailored to specific molecular targets with unprecedented precision. Furthermore, the advent of synthetic cells programmable to produce therapeutic compounds holds immense potential for revolutionizing drug discovery and personalized medicine.
From a health-care standpoint, where do you see Biochemistry leading us in the future?
It's challenging to predict with certainty, but Biochemistry will undoubtedly continue to play a central role in advancing health care. From understanding disease mechanisms to developing innovative therapeutics, our understanding of biochemical processes will drive progress in improving patient outcomes and addressing pressing health-care challenges.
What would you consider the "super power" of your department?
I believe our department's super power lies in the rigor with which we approach scientific inquiry and our collective commitment to achieving scientific excellence. This commitment permeates our research culture and is instilled in our undergraduate and graduate students, empowering them to become rigorous scientists and critical thinkers in their own right.








